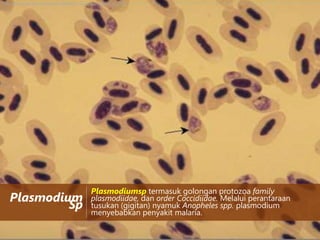
http://library.thinkquest.org/03oct/00946/pic_used/avian_plasmodium.jpg

Plasmodium
Sp

Plasmodiumsp termasuk golongan protozoa family
plasmodiidae, dan order Coccidiidae. Melalui perantaraan
tusukan (gigitan) nyamuk Anopheles spp. plasmodium
menyebabkan penyakit malaria.

Tiga dokumen tersebut membahas tentang protozoa parasit yang menyebabkan berbagai penyakit pada manusia. Dokumen menjelaskan morfologi, siklus hidup, epidemiologi, gejala, dan diagnosis laboratorium dari beberapa protozoa parasit penting seperti Entamoeba histolytica, Trichomonas vaginalis, Balantidium coli, dan Plasmodium sp.